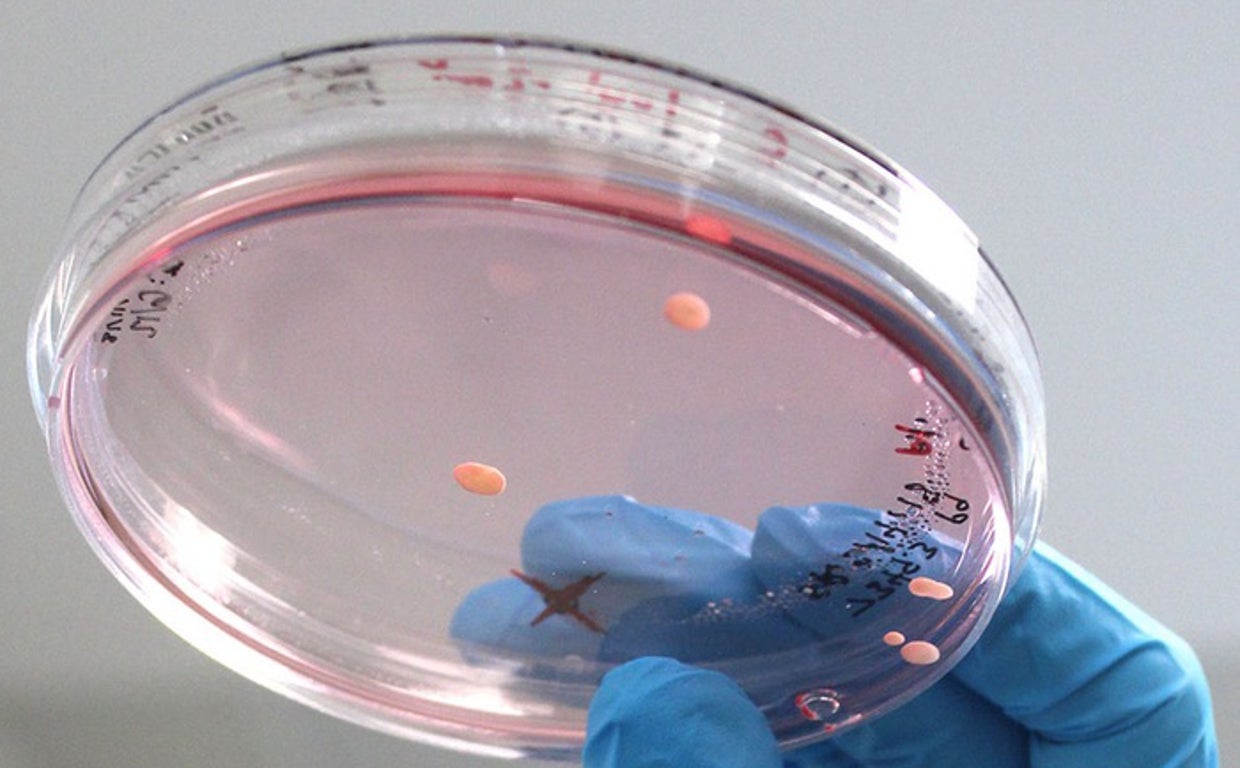
Organoides

Organoides cultivados en laboratorio revelan información sobre el autismo
Las estructuras generadas recuerdan a un pliegue de un cerebro humano de 15 a 19 semanas después de la concepción
R.I.
Madrid
Organoides del tamaño de una semilla de sésamo se cultivan en el laboratorio a partir de células humanas están proporcionando información sobre el cerebro y descubriendo diferencias que pueden contribuir al desarrollo del autismo en algunas personas.
No son «minicerebros», dicen los científicos ... de la Universidad de Utah Health. En cualquier caso, los organoides del tamaño de una semilla -que se cultivan en el laboratorio a partir de células humanas- proporcionan información sobre el cerebro y descubren diferencias que pueden contribuir al autismo en algunas personas.
«Solíamos pensar que sería demasiado difícil modelar la organización de las células en el cerebro», afirma Alex Shcheglovitov, profesor de neurobiología en U Health. «Pero estos organoides se autoorganizan. En pocos meses, vemos capas de células que recuerdan a la corteza cerebral del cerebro humano».
La investigación que describe los organoides y su potencial para entender las enfermedades neuronales se publica en «Nature Communications».
La capacidad de modelar aspectos del cerebro de este modo permite a los científicos observar el funcionamiento interno de un órgano vivo al que, de otro modo, es casi imposible acceder. Además, como los organoides crecen en una placa, pueden someterse a pruebas experimentales de un modo que no es posible en un cerebro.
El equipo de Shcheglovitov utilizó un proceso innovador para investigar los efectos de una anomalía genética asociada al trastorno del espectro autista y al desarrollo del cerebro humano. Descubrieron que los organoides diseñados para tener niveles más bajos del gen, llamado SHANK3, tenían características distintas.
Los organoides cultivados en laboratorio serán valiosos para comprender mejor el cerebro, cómo se desarrolla y qué falla durante la enfermedad
Aunque el modelo de organoide del autismo parecía normal, algunas células no funcionaban correctamente:
Las neuronas eran hiperactivas y se disparaban con más frecuencia en respuesta a los estímulos. Otros signos indicaban que las neuronas no podían transmitir eficazmente las señales a otras neuronas. Las vías moleculares específicas que hacen que las células se adhieran unas a otras estaban interrumpidas. Estos hallazgos están ayudando a descubrir las causas celulares y moleculares de los síntomas asociados al autismo, dicen los autores. También demuestran que los organoides cultivados en laboratorio serán valiosos para comprender mejor el cerebro, cómo se desarrolla y qué falla durante la enfermedad.
«Uno de los objetivos es utilizar los organoides cerebrales para ensayar fármacos u otras intervenciones que reviertan o traten los trastornos», afirma Jan Kubanek, coautor del estudio y profesor adjunto de Ingeniería Biomédica en la U.
Los científicos llevan mucho tiempo buscando modelos adecuados para el cerebro humano. Los organoides cultivados en laboratorio no son nuevos, pero las versiones anteriores no se desarrollaban de forma reproducible, lo que dificultaba la interpretación de los experimentos.
Las versiones anteriores de organoides no se desarrollaban de forma reproducible, lo que dificultaba la interpretación de los experimentos
Para crear un modelo mejorado, el equipo de Shcheglovitov se basó en el desarrollo normal del cerebro. Los investigadores hicieron que las células madre humanas se convirtieran en células neuroepiteliales, un tipo específico de célula madre que forma estructuras autoorganizadas, llamadas rosetas neuronales, en una placa. A lo largo de meses, estas estructuras se unieron en esferas y aumentaron de tamaño y complejidad a un ritmo similar al del desarrollo del cerebro de un feto en crecimiento.
Tras cinco meses en el laboratorio, los organoides recordaban a «una arruga de un cerebro humano» de 15 a 19 semanas después de la concepción, afirma Shcheglovitov. Las estructuras contenían un conjunto de células neuronales y de otros tipos que se encuentran en la corteza cerebral, la capa más externa del cerebro que interviene en el lenguaje, las emociones, el razonamiento y otros procesos mentales de alto nivel.
Una terapia génica permite a niños caminar y hablar por primera vez
R.I.Es el primer tratamiento aprobado para esta enfermedad considerada rara en Europa y la primera terapia génica que se aplica directamente en el cerebro
Al igual que un embrión humano, los organoides se autoorganizaban de forma predecible, formando redes neuronales que pulsaban con ritmos eléctricos oscilantes y generaban diversas señales eléctricas características de una variedad de tipos diferentes de células cerebrales maduras.
«Estos organoides tenían patrones de actividad electrofisiológica que se parecían a la actividad real del cerebro. No me lo esperaba», afirma Kubanek. «Este nuevo enfoque modela la mayoría de los tipos de células principales y de forma funcionalmente significativa».
Shcheglovitov explica que estos organoides, que reflejan de forma más fidedigna las intrincadas estructuras del córtex, permitirán a los científicos estudiar cómo surgen tipos específicos de células en el cerebro y cómo trabajan juntos para realizar funciones más complejas.
Esta funcionalidad es sólo para suscriptores
Suscribete
Esta funcionalidad es sólo para registrados
Iniciar sesiónEsta funcionalidad es sólo para suscriptores
Suscribete